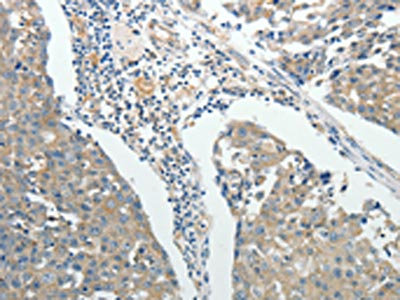

ROCK1 Antibody
-
中文名稱:ROCK1兔多克隆抗體
-
貨號:CSB-PA679461
-
規格:¥1100
-
圖片:
-
其他:
產品詳情
-
Uniprot No.:
-
基因名:
-
別名:coiled-coil-containing protein kinase 1 antibody; coiled-coil-containing protein kinase I antibody; MGC131603 antibody; MGC43611 antibody; p160 Rhoassociated coiled coil-forming protein kinase antibody; p160 ROCK-1 antibody; p160 ROCK1 antibody; p160ROCK antibody; PRO0435 antibody; Renal carcinoma antigen NY REN 35 antibody; Renal carcinoma antigen NY-REN-35 antibody; Rho associated coiled coil containing protein kinase 1 antibody; Rho associated protein kinase 1 antibody; Rho kinase antibody; Rho-alpha kinase antibody; Rho-associated antibody; Rho-associated protein kinase 1 antibody; ROCK I antibody; ROCK-I antibody; ROCK1 antibody; ROCK1_HUMAN antibody; Rok antibody; rokalpha antibody
-
宿主:Rabbit
-
反應種屬:Human,Mouse,Rat
-
免疫原:Fusion protein of Human ROCK1
-
免疫原種屬:Homo sapiens (Human)
-
標記方式:Non-conjugated
-
抗體亞型:IgG
-
純化方式:Antigen affinity purification
-
濃度:It differs from different batches. Please contact us to confirm it.
-
保存緩沖液:-20°C, pH7.4 PBS, 0.05% NaN3, 40% Glycerol
-
產品提供形式:Liquid
-
應用范圍:ELISA,IHC
-
推薦稀釋比:
Application Recommended Dilution ELISA 1:2000-1:5000 IHC 1:25-1:100 -
Protocols:
-
儲存條件:Upon receipt, store at -20°C or -80°C. Avoid repeated freeze.
-
貨期:Basically, we can dispatch the products out in 1-3 working days after receiving your orders. Delivery time maybe differs from different purchasing way or location, please kindly consult your local distributors for specific delivery time.
-
用途:For Research Use Only. Not for use in diagnostic or therapeutic procedures.
相關產品
靶點詳情
-
功能:Protein kinase which is a key regulator of the actin cytoskeleton and cell polarity. Involved in regulation of smooth muscle contraction, actin cytoskeleton organization, stress fiber and focal adhesion formation, neurite retraction, cell adhesion and motility via phosphorylation of DAPK3, GFAP, LIMK1, LIMK2, MYL9/MLC2, TPPP, PFN1 and PPP1R12A. Phosphorylates FHOD1 and acts synergistically with it to promote SRC-dependent non-apoptotic plasma membrane blebbing. Phosphorylates JIP3 and regulates the recruitment of JNK to JIP3 upon UVB-induced stress. Acts as a suppressor of inflammatory cell migration by regulating PTEN phosphorylation and stability. Acts as a negative regulator of VEGF-induced angiogenic endothelial cell activation. Required for centrosome positioning and centrosome-dependent exit from mitosis. Plays a role in terminal erythroid differentiation. Inhibits podocyte motility via regulation of actin cytoskeletal dynamics and phosphorylation of CFL1. Promotes keratinocyte terminal differentiation. Involved in osteoblast compaction through the fibronectin fibrillogenesis cell-mediated matrix assembly process, essential for osteoblast mineralization. May regulate closure of the eyelids and ventral body wall by inducing the assembly of actomyosin bundles.
-
基因功能參考文獻:
- SNHG5 acts as an oncogene in osteosarcoma via the SNHG5-miR-26a-ROCK1 axis. PMID: 30114643
- upregulation of NEAT1 may promote proliferation, migration and invasion of gastric cancer cells via targeting miR-335-5p/ROCK1 axis PMID: 29544562
- These results indicate shear stress induced vascular smooth muscle cell contraction was mediated by cell surface glycocalyx via a ROCK-MLC phosphatase (MLCP) pathway, providing evidence of the glycocalyx mechanotransduction in myogenic response. PMID: 28191820
- he phosphorylation of the MP inhibitory MYPT1(T850) and the regulatory PRMT5(T80) residues as well as the symmetric dimethylation of H2A/4 were elevated in human hepatocellular carcinoma and in other types of cancers. PMID: 28074910
- silencing of URG11 altered the expression levels of cell cycleassociated genes, epithelialmesenchymal transitionassociated genes, and RhoA and ROCK1 protein levels. Thus, the results of the present study suggest that URG11 may be a potential therapeutic target, which may be important to inhibit the development and progression of prostatic hyperplasia. PMID: 29749520
- Results suggested that the RhoA/ROCK1 pathway activated by excessive ROS is responsible for profilin-1-mediated endothelial damage. PMID: 29849894
- restoration of ROCK1 expression significantly reversed the suppressive effect of miR-361-5p on cell proliferation, migration, and invasion in papillary thyroid cancer cells. PMID: 29710554
- The pathways involved in the effect of ROCK1 in human corneal epithelial cells was preliminarily explained by detecting changes of TLR4-mediated NF-kB and ERK signaling. PMID: 29804125
- ROCK1 plays a role in oxLDL-induced cell adhesion by regulating adhesion molecules expression. PMID: 30165352
- Study showed that ROCK1 was overexpressed in retinoblastoma (RB) tissues and inversely correlated with miR448 expression. Furthermore, ROCK1 silencing induced effects on the proliferation, invasion and apoptosis of RB cells similar to those observed following miR448 overexpression. Importantly, miR448 targeted ROCK1 to inhibit the activation of the PI3K/AKT signaling pathway in RB. PMID: 29517104
- These results suggested a protective role of miR-145 in high glucose-treated vascular smooth muscle cells by suppressing ROCK1. PMID: 29324316
- the level of ROCK1 was markedly increased in osteosarcoma cancer tissues compared to that of noncancerous tissues. PMID: 29441962
- The underlying molecular mechanism of dasatinib-induced reorganization of the actin involves ROCK activation, which increases the amount of the phosphorylation of myosin light chain and consequently activates the non-muscle myosin II. PMID: 28821556
- NEAT1 promoted ovarian cancer cells metastasis through regulating the miR-382-3p/ROCK1 axis PMID: 29790629
- Data demonstrate that miR-148a acts as a tumor suppressor in OS, at least partly, via targeting ROCK1. PMID: 28117029
- We identify HGF, acting through the c-Met receptor, as the key polarity-inducing morphogen, which acts to activate b1-integrin-dependent adhesion. HGF and ECM-derived integrin signals co-operate via a c-Src-dependent inhibition of the RhoA-ROCK1 signalling pathway via p190A RhoGAP PMID: 28888686
- data suggest that TGF-beta stimulated the expression of ChPF and sGAG synthesis in nucleus pulposus cells through Smad3, RhoA/ROCK1 and the three MAPK signaling pathways. PMID: 28608941
- RhoA is activated in tumors from neuroblastoma patients, and elevated expression of Rho-associated kinase (ROCK)2 is associated with poor patient survival. Pharmacological or genetic inhibition of ROCK1 and 2, key molecules in Rho signaling, resulted in neuroblastoma cell differentiation and inhibition of neuroblastoma cell growth, migration, and invasion. PMID: 28739902
- Knockdown of ROCK1 decreased the volume and weight of the xenograft tumors, while overexpression of ROCK1 showed a proliferative tendency with significantly greater tumor volume and weight in vivo. The upregulation of ROCK1 increased the expression of MMP-9, and levels of MMP-9 positively correlated with the ROCK1 levels in PTC tissues. PMID: 28848996
- ROCK1 and ROCK2 contribute to the genetic susceptibility of hypertension and stroke. PMID: 29246448
- Our findings revealed that ROCK1 was overexpressed in malignant vascular tumors such as hemangioendotheliomas and angiosarcomas, and ROCK2 was overexpressed in both benign and malignant vascular tumors including hemangiomas, hemangioendotheliomas, hemangiopericytomas, and angiosarcomas. shRNA-mediated knockdown of ROCK2, but not ROCK1, in xenograft vascular tumors significantly reduced tumor size and proliferative index PMID: 28709411
- MicroRNA-146a suppresses ROCK1 allowing hyperphosphorylation of tau in Alzheimer's disease. PMID: 27221467
- The migration of dermal endothelial cells undergoing epithelial-mesenchymal transition is dependent on both extracellular matrix degradation and invadosome formation associated with MMP-2 proteolytic activity and Rho/ROCK cytoskeleton contraction. PMID: 28487031
- ROCK inhibitor Y-27632 cooperated with Myc to immortalize keratinocytes efficiently, indicating that apoptosis is a major barrier to Myc-induced immortalization of keratinocytes. PMID: 27556514
- Combined EGFR and ROCK inhibition effectively blocks proliferation of triple-negative breast cancer (TNBC) cells. PMID: 27374095
- Inhibition of ROCK signaling restored polarity, decreased disorganization of F-actin, and led to reduction of proliferation of breast cancer cells. PMID: 27203208
- Data show that ROCK1 is the direct target of miR-300, and that the 3' UTRs of ROCK1 had at least 7 nucleotides that were complementary to the miR-300 seed region. PMID: 27145462
- OB-Rb, RhoA/ROCK, PI3K/AKT, JAK/STAT pathways and NF-kB activation are involved in leptin-induced upA expression. PMID: 28104444
- Dexamethasone up-regulates ROCK1/2 activity promoting migration, invasion and metastasis of melanoma cells. PMID: 28923399
- Intercellular adhesion-dependent cell survival and ROCK-regulated actomyosin-driven forces are required for the self-organization. Our data supports a hypothesis that newly specified neuroretina progenitors form characteristic structures in equilibrium through minimization of cell surface tension. PMID: 27132890
- SNRK in cardiomyocytes is responsible for maintaining cardiac metabolic homeostasis, which is mediated in part by ROCK, and alteration of this homeostasis influences cardiac function in the adult heart. PMID: 27780848
- data suggests that ROCK1 may serve as a potential therapeutic target to enhance current treatment regimens for pancreatic cancer PMID: 28841710
- Genetic variant in ROCK1 gene is associated with progression of prostate cancer. PMID: 28184030
- Results showed that ROCK1 gene rs2271255 (Lys222Glu), rs35996865, and ROCK2 gene rs726843, rs2290156, rs10178332, rs35768389 (Asp601Val) polymorphisms were significantly associated with respiratory distress syndrome (RDS), and that they could be a risk factor for development of neonatal RDS. PMID: 27269648
- These findings reveal an ancillary role for increased ROCK signaling in pancreatic cancer progression to promote extracellular matrix remodeling that facilitates proliferation and invasive tumor growth. PMID: 28031255
- Despite sharing the catalytic domain with ROCK2, ROCK1 appears to be the dominant kinase essential for junctional integrity and contractile tension at epithelial ZA. PMID: 28035042
- High ROCK1 expression is associated with Clear cell renal cell carcinoma. PMID: 27841867
- Studies showed that ROCK isoforms, ROCK1 and ROCK2, have been found in various types of neuron-like cell lines and neurons, and function as different regulators in axon outgrowth, neurite retraction, cell survival, autophagy, energy balance, and generation of endogenous beta amyloid. [review] PMID: 27033194
- These results indicate the differential role of ROCK isoforms in myofibroblast differentiation on soft and stiff matrices. PMID: 28225294
- BCR-ABL-dependent ROCK, but not TK, is involved in CD1d downregulation. We propose that ROCK, which is most likely activated by the DH/PH domain of BCR-ABL, mediates iNKT-cell immune subversion in chronic myeloid leukaemia (CML) patients by downregulating CD1d expression on CML mDCs. PMID: 27513300
- that reduction of ROCK1 diminishes amyloid-beta levels by enhancing Amyloid beta-Protein Precursor protein degradation PMID: 27246255
- Silencing Drp1 inhibits glioma cells proliferation and invasion by RHOA/ ROCK1 pathway. PMID: 27495873
- RhoB and ROCK play a key role in preeclampsia. PMID: 27324125
- These data provide molecular insight into the Shroom-Rock interface and demonstrate that Shroom directly participates in regulating cytoskeletal dynamics, adding to its known role in Rock localization. PMID: 27758857
- We successfully identified a novel pathway via which SIN exerted antioxidative and renal protective functions, and provided a molecular basis for potential SIN applications in treating DN vascular disorders. PMID: 27378427
- The results of the present study indicate that miR126 inhibits RCC cell proliferation, migration and invasion by downregulating ROCK1. PMID: 27108693
- ROCK1 gene and ROCK protein expressions may contribute to the development of MCL. PMID: 26377148
- miR-214-5p was identified as a new tumor suppressor, which directly targeted ROCK1 and suppressed proliferation of human OS cells. PMID: 28081735
- vThese results suggest that ROCK may be important in IL-1-induced signaling through MKK4 to JNK and the activation of p38 MAPK. PMID: 27173611
- There are 2 isoforms: ROCK1 and ROCK2. They have different functions in different types of cells and tissues. There is growing evidence that ROCKs contribute to the development of cardiovascular diseases, including cardiac fibrosis, hypertrophy, and subsequent heart failure. PMID: 27251065
顯示更多
收起更多
-
亞細胞定位:Cytoplasm. Cytoplasm, cytoskeleton, microtubule organizing center, centrosome, centriole. Golgi apparatus membrane; Peripheral membrane protein. Cell projection, bleb. Cytoplasm, cytoskeleton. Cell membrane. Cell projection, lamellipodium. Cell projection, ruffle.
-
蛋白家族:Protein kinase superfamily, AGC Ser/Thr protein kinase family
-
組織特異性:Detected in blood platelets.
-
數據庫鏈接:
Most popular with customers
-
-
YWHAB Recombinant Monoclonal Antibody
Applications: ELISA, WB, IHC, IF, FC
Species Reactivity: Human, Mouse, Rat
-
Phospho-YAP1 (S127) Recombinant Monoclonal Antibody
Applications: ELISA, WB, IHC
Species Reactivity: Human
-
-
-
-
-